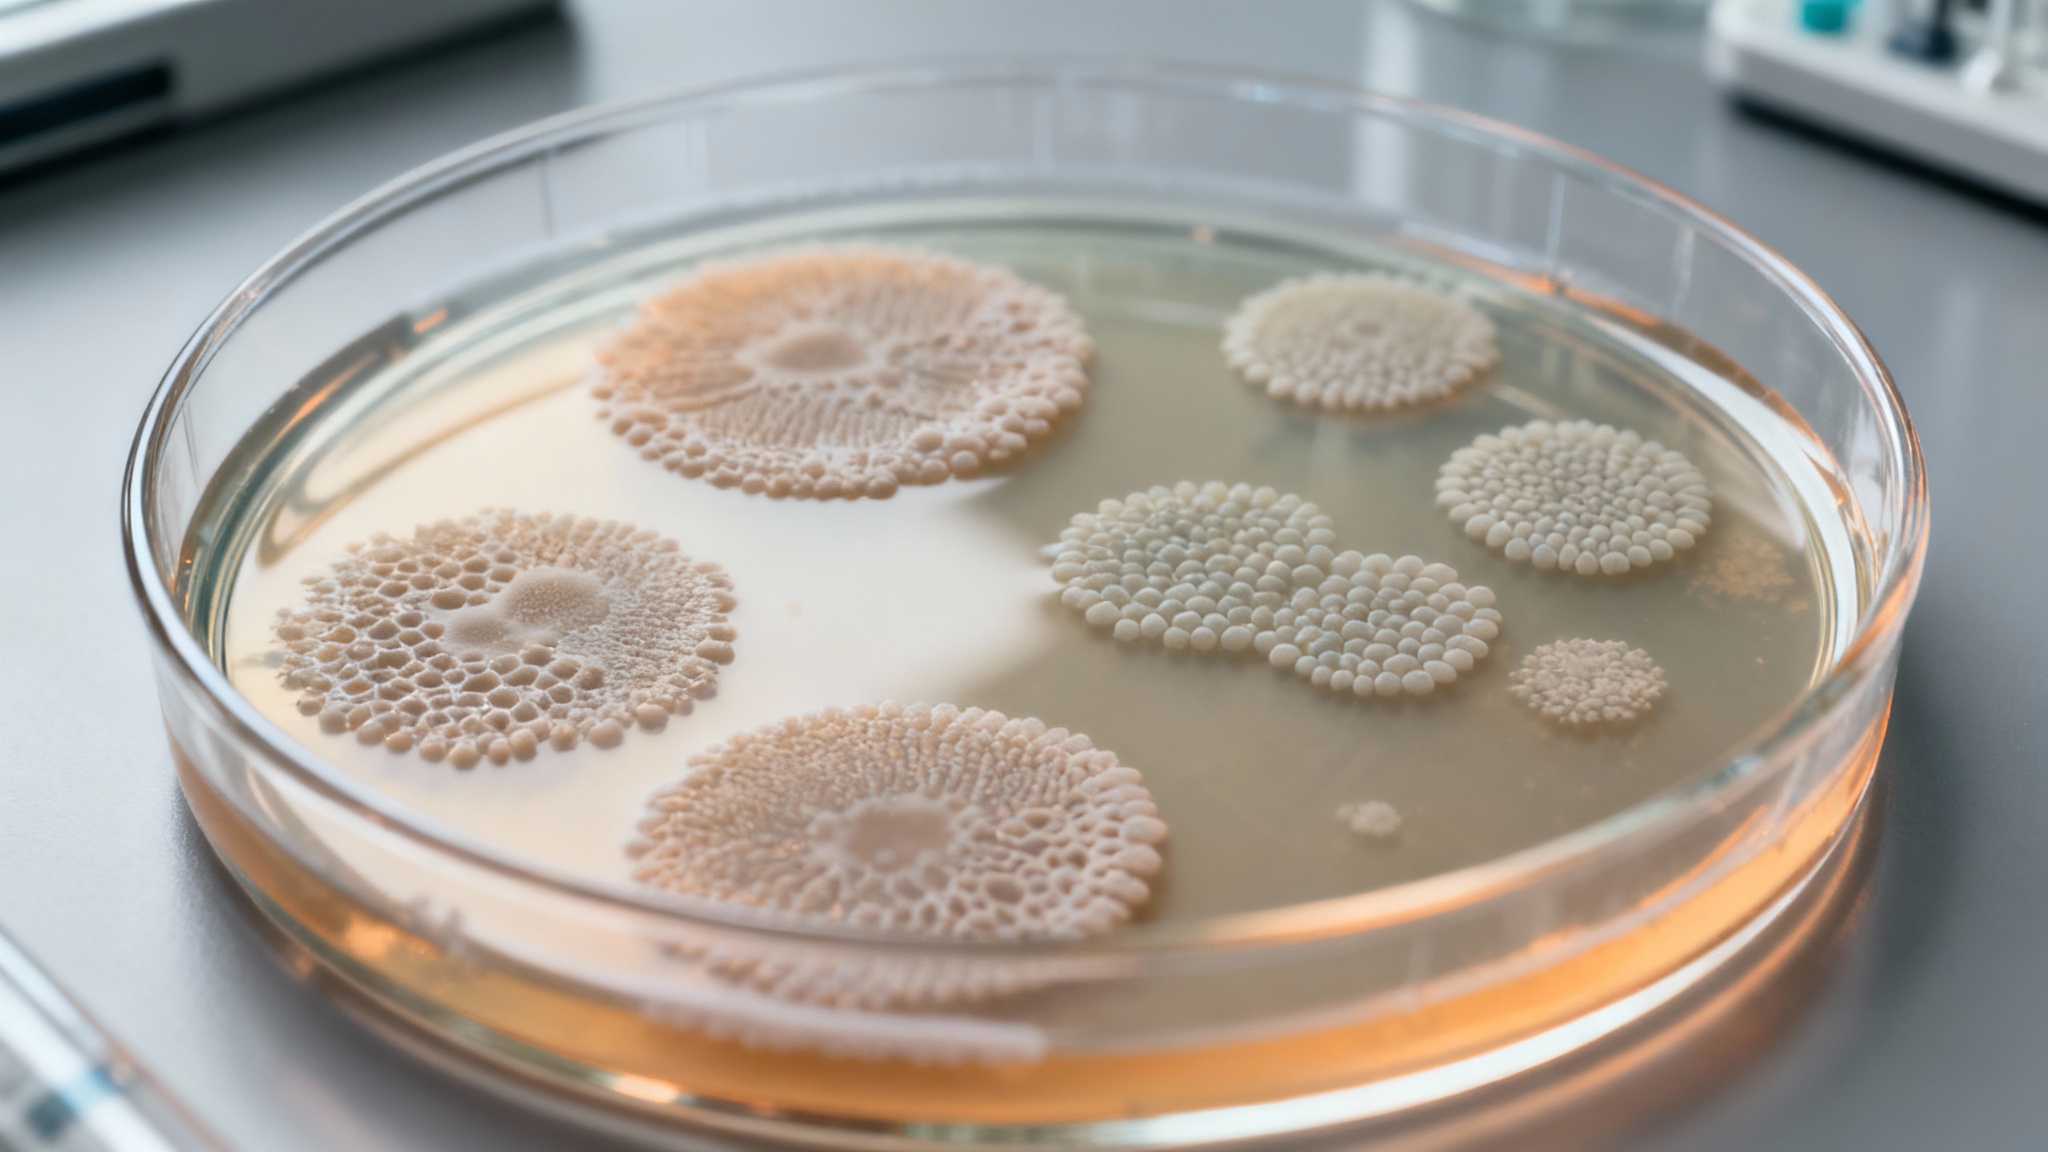
Le tour de passe-passe des microbes pour une production durable

La superpuissance des céphalopodes bientôt dans nos vies : quand la science recrée le camouflage
Auteur: Mathieu Gagnon
Mais comment capturer cette magie de la nature pour l’intégrer à notre quotidien ? C’est une histoire fascinante d’astuce génétique et de microbes affamés.
Le secret du camouflage : l'art de se fondre dans la masse

Cette prouesse est gérée par plusieurs structures dans la peau, mais le cœur de la couleur réside dans des cellules spécifiques appelées chromatophores. Ces petits sacs contiennent différents pigments—y compris des caroténoïdes et de la mélanine—qui permettent à l’animal d’imiter les teintes et la luminosité de son environnement.
La xanthommatine, un pigment aux propriétés uniques

Depuis longtemps, l’humanité cherche à exploiter cette xanthommatine pour ses qualités uniques de changement de couleur et de protection. Le problème, c’est que la prélever directement sur les poulpes et les seiches est incroyablement inefficace. Et jusqu’à récemment, les méthodes pour la reproduire en laboratoire étaient à peine meilleures. On était bloqué, vous voyez, par le côté fastidieux de la récolte.
Le tour de passe-passe des microbes pour une production durable
Leur idée ? Utiliser la biologie synthétique pour convaincre des microbes de faire le travail à leur place. La chercheuse Leah Bushin, qui a dirigé l’équipe, a expliqué que malgré toutes ses promesses (écrans, teintures, protection UV), la xanthommatine n’avait jamais été produite efficacement dans une « usine cellulaire ». Mais cela allait changer.
Le piège à bactéries et le facteur formate

Donc, voici le piège : les bactéries ne pouvaient survivre et croître que si elles fabriquaient la xanthommatine, car sans elle, elles n’avaient plus le formate nécessaire. La nature humaine est parfois ingénieuse, mais la nature microbienne forcée l’est encore plus. Laissées seules pendant la nuit, ces bactéries, contraintes par cette boucle de croissance obligatoire, ont produit la xanthommatine à un niveau spectaculaire.
Un rendement multiplié par mille et l'aide de la robotique

Le résultat est stupéfiant : les chercheurs ont réussi à produire jusqu’à mille fois plus de xanthommatine que toutes les autres méthodes de laboratoire utilisées précédemment. Mais ce n’est pas qu’une question de quantité. Utiliser des bactéries génère une coloration qui est considérée comme un « matériau vivant » et qui pourrait être beaucoup plus sûre et écologique pour notre planète à l’avenir.
Des crèmes solaires aux gadgets intelligents : des applications concrètes

Mais, plus important encore, la xanthommatine est précieuse pour l’industrie cosmétique. Elle pourrait être utilisée dans des crèmes solaires minérales, afin d’étendre significativement la protection contre les rayons UV. Elle a aussi un rôle à jouer dans les gadgets technologiques. On parle de capteurs solaires portables qui changeraient de couleur s’ils détectaient une exposition excessive au soleil. Des prototypes de toutes ces technologies sont déjà en cours de développement.
Vers des biomatériaux vraiment vivants

Grâce aux propriétés optoélectroniques de la xanthommatine, les chercheurs explorent activement son potentiel dans ce domaine des matériaux vivants. Bientôt, cette technologie bio-conçue pourrait permettre aux humains d’enfiler une veste et de se transformer, un peu comme les céphalopodes, même si, je vous rassure, les tentacules restent facultatifs ! C’est une belle illustration de la manière dont la nature inspire nos plus grandes innovations scientifiques.
Selon la source : popularmechanics.com






